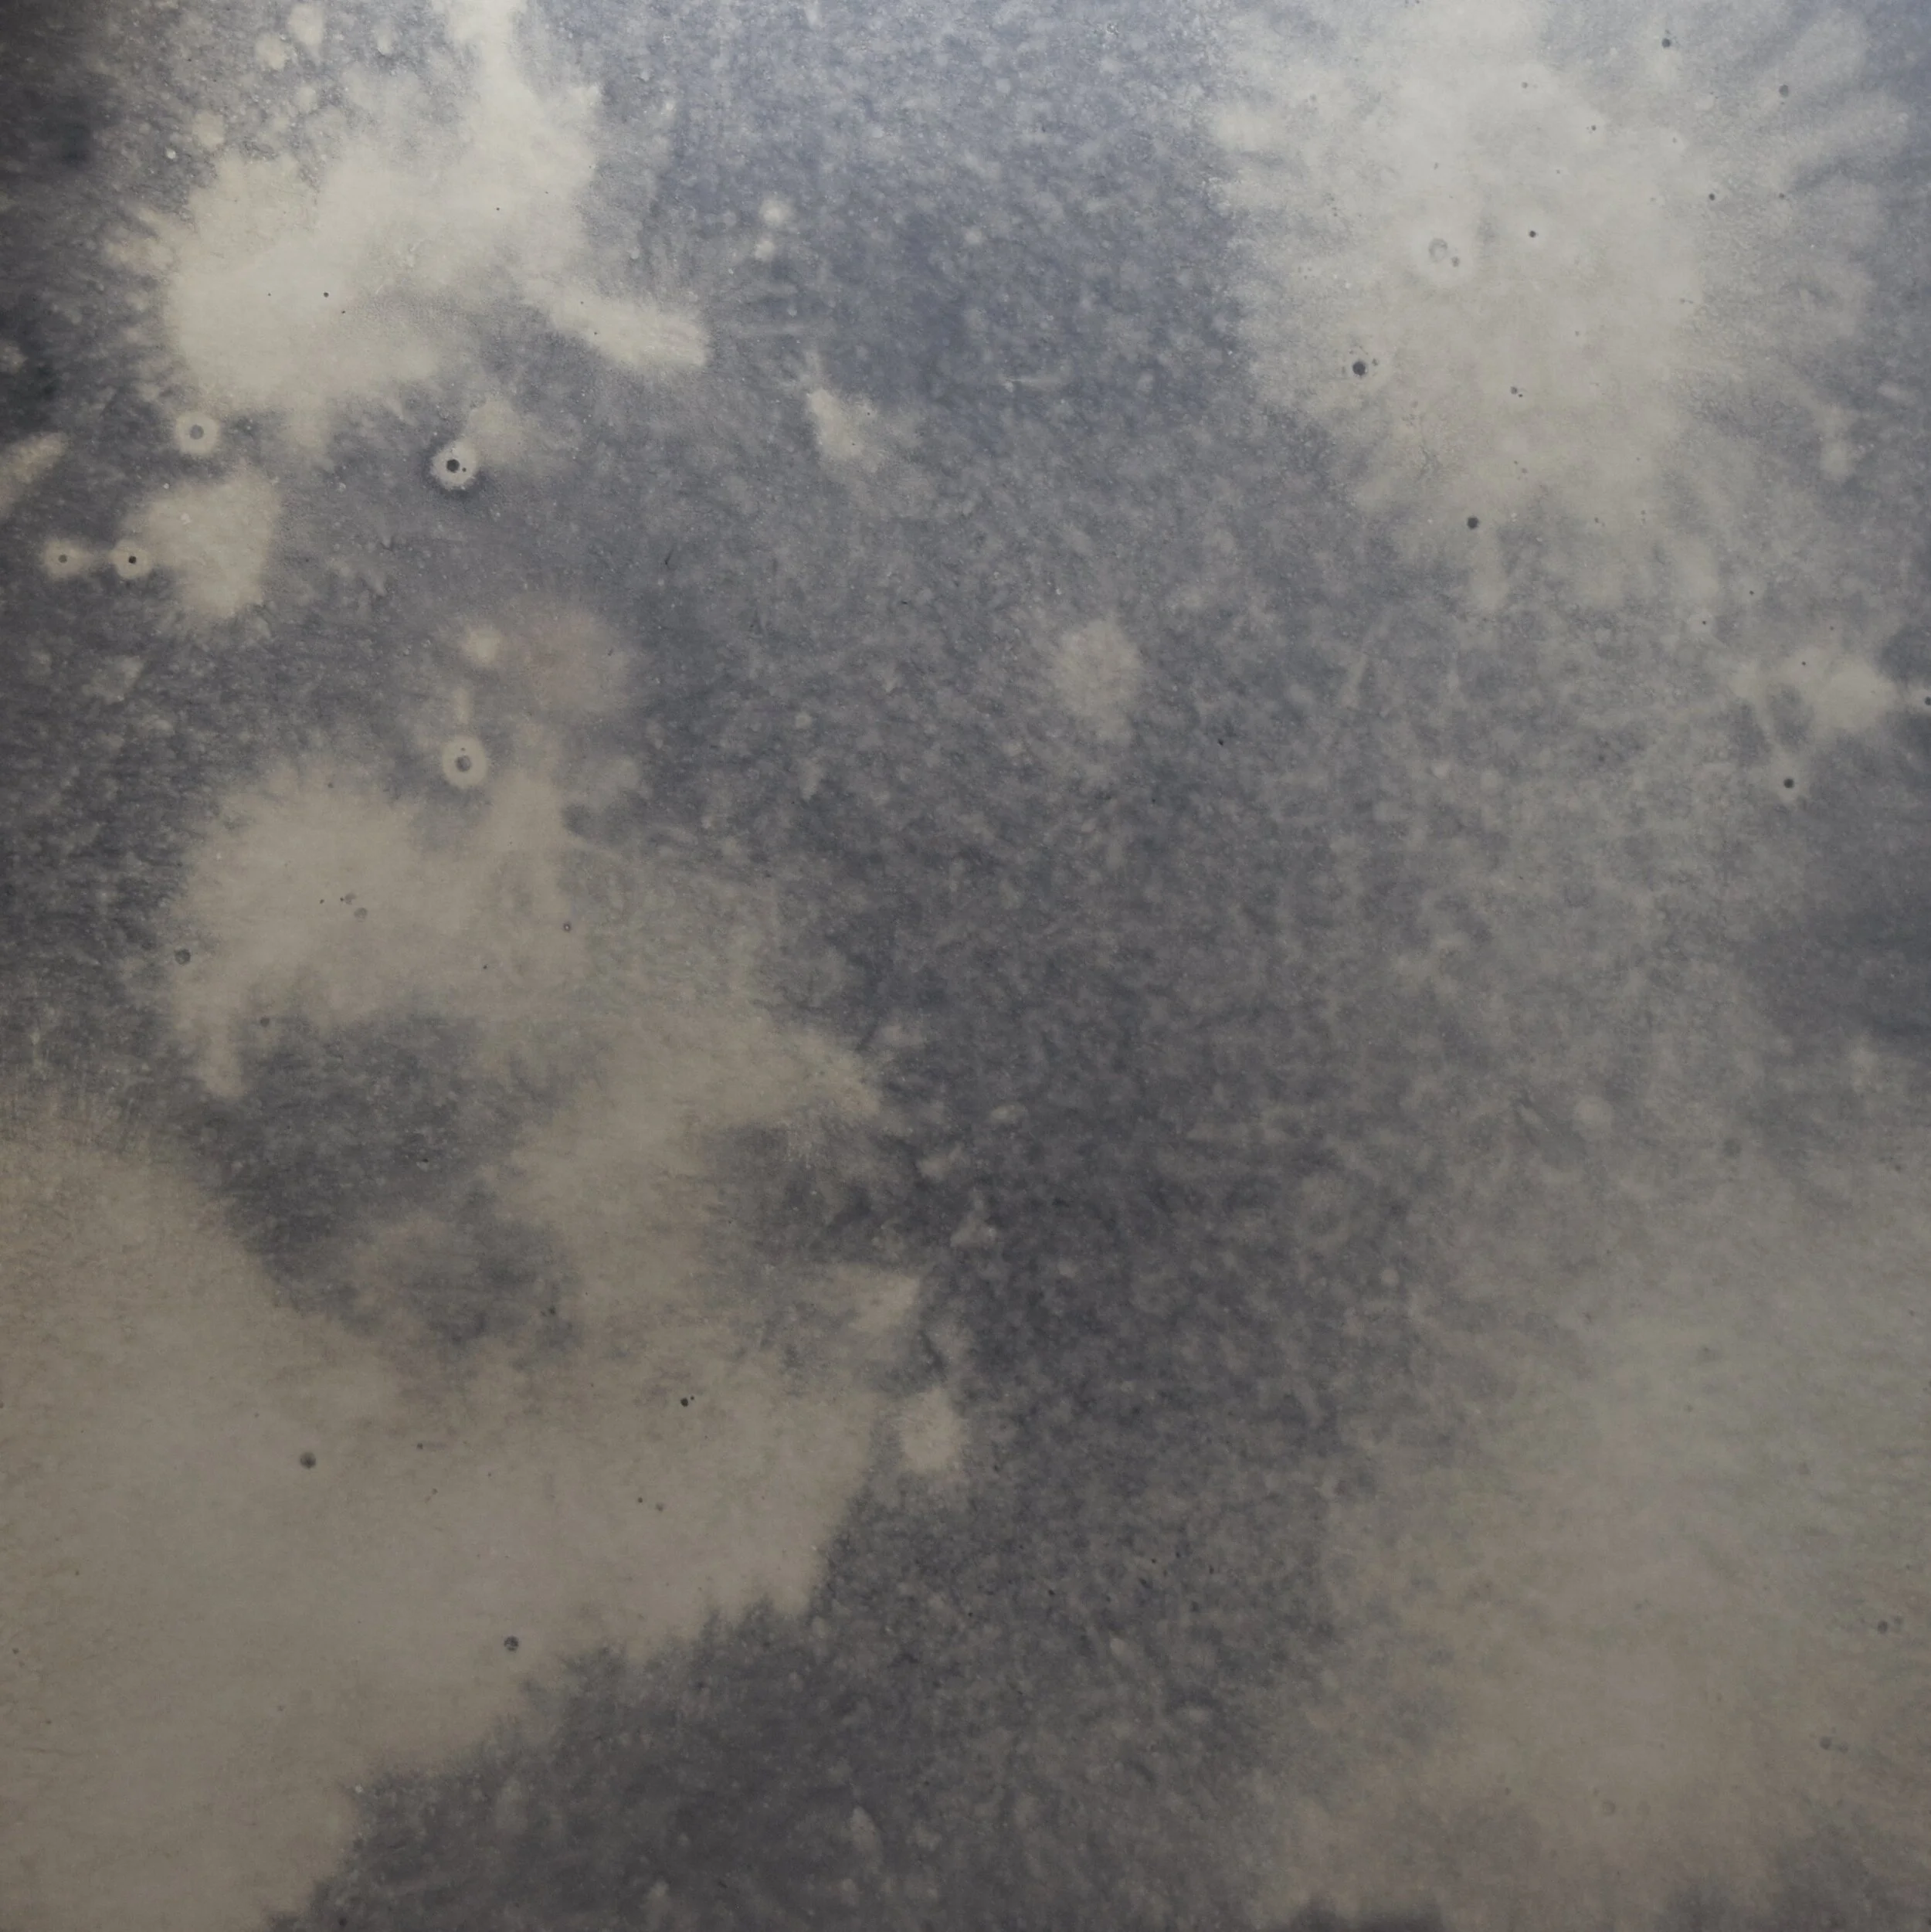

Glass & MirrOr
We work with clear and extra clear glass and also mirror with various antiquing effects
Glass
We are able to use most types of glass for projects, and work with clear and extra clear glass, but also back-painted glass, which can have a sandblasted finish. We can paint the back of the glass to be any RAL colour, but the tint of the glass will need to be accounted for as this can change the colour slightly.
MirrOr
We work with all glazed surfaces, and this includes mirror, and in particular, antique mirror. Quite often we will work directly with suppliers of these specialist finishes an co-ordinate with them when a project requires these.